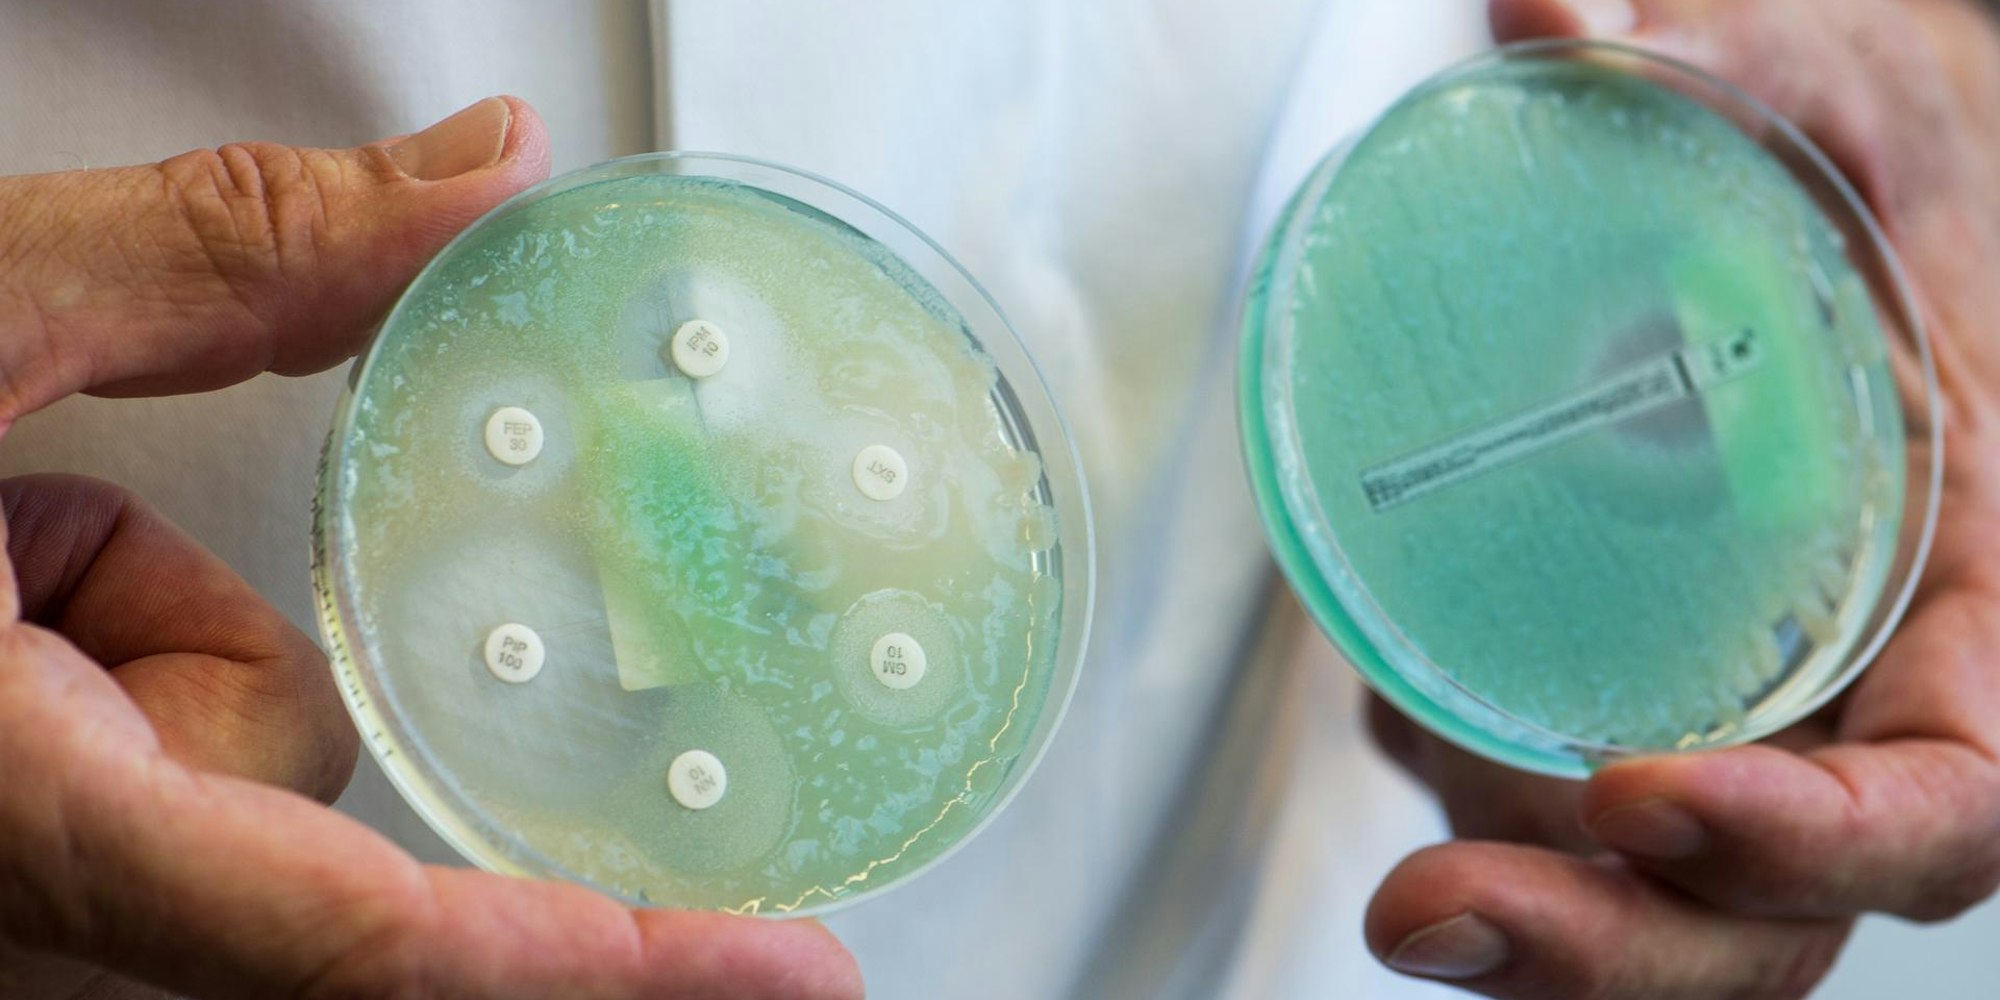
Keime dpa

Staatsanwaltschaft ermitteltKölner stirbt nach Behandlung in Klinik – Keiminfektion
Petrischalen mit Keimen (Symbolbild)
Copyright: picture alliance/dpa
- 28 Menschen, die sich im Medizinischen Versorgungszentrum (MVZ) am Neumarkt einer Behandlung unterzogen haben, mussten danach wegen einer Infektion mit einem Keim behandelt werden.
- Ein Mann ist sogar gestorben. Nun ermittelt die Staatsanwaltschaft.
- Besteht die Gefahr weiterhin? Wir beantworten die wichtigsten Fragen.
Kölner Innenstadt – Sie erhofften sich Linderung, aber es kam ganz anders: 28 Menschen, die sich im Medizinischen Versorgungszentrum (MVZ) am Neumarkt einer Behandlung der Wirbelsäule mittels Injektionen unterzogen haben, mussten danach wegen einer Infektion mit einem Keim behandelt werden. Die Folge waren unter anderem Hirnhautentzündungen, ein Mann (84) starb.
Genau diese Frage versucht zur Zeit das Gesundheitsamt zu klären, hat aber noch keine Antwort. Gerhard Wiesmüller, der stellvertretende Leiter und selbst Bakteriologe ist: „Wir sind noch im Ermittlungsverfahren.“ Es fehle noch eine deutliche Verbindung zwischen den Informationen, die vom Patienten gewonnen, und denen, die aus der Umwelt gewonnen werden. Mit anderen Worten: Der Keim, dessentwegen die Patienten – unter anderem in der Uniklinik – behandelt wurden, konnte noch nicht in der Radiologie-Praxis gefunden werden.
WAS IST DAS FÜR EIN KEIM?
Die Staatsanwaltschaft spricht von einem „Wasserkeim“, doch selbst dazu liegen laut Wiesmüller noch keine gesicherten Erkenntnisse vor. Nur soviel: „Es ist ein Umweltkeim.“ Also ein Keim, der in der Umwelt des Menschen vorkommt. So genannte „Feuchtpfützenkeime“ zum Beispiel halten sich im Wasser auf, das kann im Waschbecken oder im Toilettenrand sein. Andere Keime, zum Beispiel der multiresistente MRSA-Keim, überleben auch auf trockenen Oberflächen. Doch auch die Frage, ob es sich um einen antibiotikaresistenten Keim handele, kann Wiesmüller noch nicht beantworten.
BESTEHT NOCH GEFAHR?
„Nein“, sagt Wiesmüller, „die Gefahr in dieser Praxis ist gebannt“, sagt Wiesmüller. Das MVZ führt die Injektionsbehandlung, nach der es bei den Patienten zu Komplikationen kam, zur Zeit nicht durch. „In solchen Fällen untersagen wir generell, die Behandlungs- und Untersuchungsmaßnahmen, bei denen es zu einer Infektion kam, weiter durchzuführen“, erklärt Wiesmüller. Generell könne sich aber niemand grundsätzlich vor Umweltkeimen schützen, da sie überall vorhanden sind.
WAS FÜR EINE BEHANDLUNG?
Bei der CT-gesteuerten periduralen Infiltrations-Therapie sieht der Arzt im Computer-Tomographen die Wirbel des Patienten und kann eine Spritze, zum Beispiel mit Cortison, millimetergenau an Nerv und Wirbel setzen.
WANN HABEN SICH DIE PATIENTEN INFIZIERT?
Laut Medienberichten soll es sich um den Zeitraum vom 18. Januar bis zum 8. Februar handeln.
WIE WURDE DIE HÄUFUNG DER INFEKTIONEN ENTDECKT?
Im Uniklinikum häuften sich die Fälle, in denen Patienten aufgrund einer Infektion mit dem Keim behandelt wurden, die zuvor in der Radiologie-Praxis die CT-gesteuerte Infiltrations-Therapie gemacht hatten.
WARUM ERMITTELT DIE STAATSANWALTSCHAFT KÖLN?
Einer der Patienten des MVZ ist gestorben. „Bei der Staatsanwaltschaft Köln ist ein Todesermittlungsverfahren anhängig“, so Pressesprecher Ulrich Bremer, wegen eines Patienten, der „sich offenbar nach ärztlicher Behandlung wegen Rückenschmerzen mit einem sog. Wasserkeim infiziert hatte“. Laut Obduktionsbericht verstarb der Patient später an einem Multiorganversagen. Die Todesursache sei derzeit ungeklärt. „Ob die ursprüngliche Infektion mit dem Wasserkeim todesursächlich war, ist Gegenstand der Ermittlungen“. Unter anderem würden Krankenunterlagen ausgewertet. Gegen konkrete Beschuldigte werde derzeit nicht ermittelt.
WAS SAGT DIE PRAXIS?
Deren ärztlicher Geschäftsführer, Dr. Michael Herbrik, bestätigt die Vorgänge, möchte sich aber mit Verweis auf das laufende Ermittlungsverfahren nicht weiter dazu äußern.
WAS SAGEN EXPERTEN?
Hygiene- und Infektionsexperten halten das Auftreten eines gefährlichen Bakteriums in der Kölner Praxis für dramatisch. Sollte sich bestätigen, dass sich mindestens 28 Patienten in der Praxis mit Pseudomonas aeruginosa infiziert haben, wäre es „meines Wissens einer der schwerwiegendsten Vorfälle mit diesem Erreger in einer ambulanten Einrichtung in Deutschland, wenn nicht sogar in Europa“, sagte der Infektiologe Peter Walger. Er ist Vorstandssprecher der Deutschen Gesellschaft für Krankenhaushygiene. Infektionen mit dem Keim in Praxen oder Kliniken gäbe es in Europa immer wieder, sagte Mikrobiologe Alexander Friedrich von der Universität Groningen in den Niederlanden. „Meist betrifft es einen einzelnen Patienten, in den meisten publizierten Fällen weniger als zehn Patienten“, sagte er. Nur selten seien es mehr. (mit dpa)